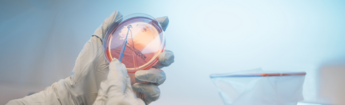

Bem-vindo à Galderma Brasil

Selecione uma seção
Bem-vindo à Galderma Brasil
A pele de cada pessoa é única e cada um de nós tem a sua própria história de pele. Na Galderma, abraçamos essas diferenças e oferecemos marcas premium de ponta que atendem às necessidades individuais de consumidores e pacientes, em todo o espectro da dermatologia.
Aproveitando nossa herança única de mais de 40 anos de inovação com base na ciência e com presença em mais de 90 países, oferecemos um portfólio integrado, com marcas que ocupam posições de liderança de mercado em suas respectivas categorias de produtos.
Fornecemos um portfólio inovador e baseado na ciência de marcas e serviços premium que abrangem todo o espectro do mercado de dermatologia, concentrando-se em três pilares estratégicos:
- Estética Injetável
- Skincare Dermatológico
- Dermatologia Terapêutica
Entendemos que a pele em que estamos molda nossas histórias de vida. Por isso, temos como propósito:
Avançar a Dermatologia para Cada História de Pele
Diferenciais
Portfólio Integrado de Dermatologia
Estética Injetável
Skincare Dermatológico
Dermatologia Terapêutica
Presença a nivel mundial
50 escritórios espalhados em 40 países, com sede global na Suíça
4 Centros de Distribuição
A Galderma conta com centros de fabricação no Canadá, Suécia, França e Brasil. A unidade do Brasil, em Hortolândia, São Paulo, é responsável pelo abastecimento de toda a América Latina, EUA e alguns países da Europa, Ásia, Oceania e África, abrangendo cerca de 39 países no total.
Fábrica em Hortolândia - SP
Contamos com zero desperdício em nossa fábrica, e 100% de nossa energia é verde. Compensamos as emissões de CO2 na fábrica por meio do projeto "Floresta Amazônica do Acre", reduzindo o desmatamento e a degradação florestal. Contamos também com um programa de Logística Reversa das embalagens após o uso e com redução de 20% de água, com a reutilização de água do processo produtivo.
Estética Injetável

O segmento de mercado de Estética Injetável é grande, atraente e possui fortes fundamentos de crescimento. Com a nossa presença em preenchedores e bioestimuladores, a Galderma está idealmente posicionada para capitalizar este crescimento.
Nosso objetivo é causar impacto na vida dos consumidores, fornecendo soluções estéticas inovadoras e eficazes. Oferecemos aos nossos clientes tratamentos, serviços e educação para ajudá-los a obter os melhores resultados que melhoram sua pele e atendem às suas necessidades individuais.
Temos uma longa história de inovação estética e uma vasta experiência em preenchimentos de ácido hialurônico (AH) e bioestimuladores. Já estabelecidos como a empresa líder em dermatologia pura, continuamos a expandir o nosso portfólio de marcas premium recomendadas por profissionais de saúde – Restylane® (Ácido Hialurônico Injetável) e Sculptra® (bioestimulador de colágeno).
Para saber mais: https://www.galdermaaesthetics.com.br/
Para garantir sua segurança e a autenticidade, para produtos injetáveis, utilize sempre os nossos canais de venda diretos. Você pode comprar via Distribuidores Homologados ou via My Galderma Store. Lá você encontra nossos produtos com segurança, praticidade e benefícios exclusivos.
Skincare Dermatológico

O segmento de Skincare Dermatológico compreende as marcas Cetaphil® e Alastin®, que oferecem soluções baseadas na ciência e recomendadas por dermatologistas que ocupam posições de liderança no mercado.
Em nossa categoria de Skincare Dermatológico, nosso objetivo é fornecer aos consumidores tratamentos cosméticos inovadores e baseados na ciência para manter a pele saudável ao longo de suas vidas. Desde formulações e embalagens até áreas e canais terapêuticos, estamos sempre em busca de inovar. Desta forma, podemos continuar a fornecer marcas e serviços que atendam às crescentes necessidades da pele das pessoas.
Para saber mais sobre Cetaphil®, acesse: https://www.cetaphil.com.br/
Para saber mais sobre Alastin®, acesse: https://alastin.com.br/
Dermatologia Terapêutica
O segmento de mercado de Dermatologia Terapêutica abrange tratamentos prescritos que visam condições de pele moderadas a graves. A Galderma possui um amplo portfólio e um compromisso com o desenvolvimento de novas terapias em diversas áreas de doenças com necessidades médicas não atendidas. Mantemos posições de liderança em tratamentos de acne e rosácea.
Em Dermatologia Terapêutica, a Galderma oferece soluções para doenças de pele, como:
- Acne
- Rosácea
- Dermatite Atópica
- Micose de Unha
- Psoríase
Além disso, conta com a linha Dermotivin®, marca voltada especialmente para o público brasileiro e com o propósito de valorizar a singularidade de cada pele. Entendemos a limpeza da pele e o ato de lavar o rosto conectados com o princípio de bem-estar, e os sabonetes faciais Dermotivin® se encaixam no cuidado diário e desejam ser e estar presentes todos os dias na vida dos seus consumidores.
Para saber mais sobre a linha Dermotivin®, acesse: https://www.dermotivin.com.br/
Trabalhe na Galderma Brasil
A Galderma valoriza e promove a diversidade. Aqui, cada indivíduo traz à mesa suas próprias habilidades, ideias e paixões enquanto colaboramos para melhorar a qualidade de vida de pessoas com diversas necessidades de pele.
Visite nossa página de carreiras para saber mais sobre como você pode se juntar à nossa equipe e ajudar a avançar a dermatologia para cada história de pele.
Informações Legais
Relatório de Trasparência e Igualdade Salarial
Reservamo-nos o direito de fazer quaisquer alterações e correções neste aviso. Consulte esta página de tempos em tempos para revisar essas e novas informações adicionais.
Direitos autorais © 2025 Galderma S.A.




